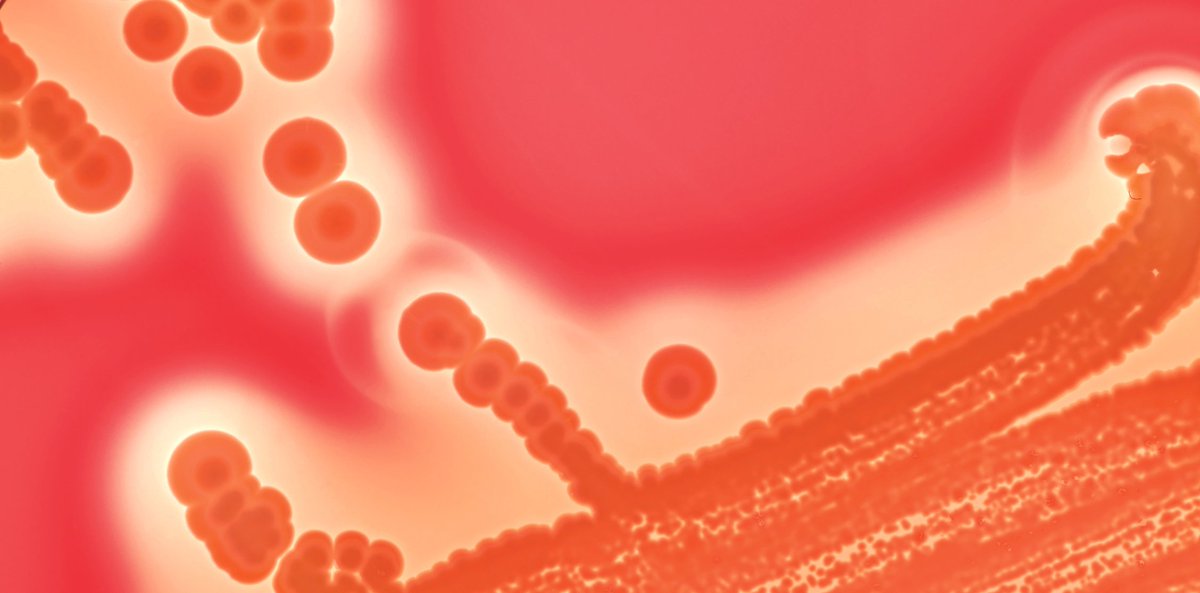
PittMedMag's tweet image. “Seeing evolution happen in real time is just so captivating,” says @vscooper, a professor @PittHealthSci &amp;amp; founder of @EvolvingSTEM, which provides high school students with an evolution-in-action 3D curriculum and kit. #ScienceTwitter #highschoolscience pi.tt/mutantsummer

#highschoolscience search results
We are super excited to join @SystemsSally in Cambridge, MA today for a workshop to introduce #highschoolscience teachers to the @genesinspace contest – where students design DNA experiments to be conducted in space! lnkd.in/edAafwq #STEMeducation #GenesInSpace
Calling all #highschoolscience students and #teachers... did you know there is still time to complete your #GenesInSpace application? Applications are due April 25th... Have a hypothesis about what happens to #DNA in space? @genesinspace @ISS_CASIS genesinspace.org
Calling all #highschoolscience teachers and students. Join @genesinspace today, March 25 at 3pm ET, to hear the comprehensive guide to the Genes in Space competition from Dr. Alex Dainis. Tune to get the lowdown on this year's contest. nebiolabs.com/2JdfwWl
Today I had a wonderful time talking to the exceptionally bright students in Hunter College High School's Psychology Club about science and the 🧠! Thank you for the invite! #stem #highschoolscience #scicomm #Science

Calling #highschoolscience teachers! Join @SystemsSally in Cambridge, MA at @labcentral for a workshop to introduce you to @miniPCR Genes in Space contest – where students design DNA experiments to be conducted in space! bit.ly/GenesinSpaceWo… #STEMeducation #GenesInSpace
I look into the finance box Just to check my status I look into the microscope See Golgi Apparatus Golgi, oh, woe is me You can't even see the sea Golgi, olgi, oh ooo olgi Golgi Golgi @phish @phishlyrics101 #science #highschoolscience … ift.tt/2BZXwv4

The Maine State Science Fair is taking place on March 26 & we couldn’t be more excited! Jeffrey Hall is one of many innovators with a connection to Maine. Stay tuned for more fun facts for #MSSF2022! #stemeducation #highschoolscience #sciencefair

Ms. Brown's college prep biology class is finishing up their unit on animal diversity by dissecting earthworms, starfish, and frogs. Says Ms. Brown, "I am quite impressed with their curiosity and eagerness to learn more!" #biology #highschoolscience


[Book Excerpt] Simple Science for Homeschooling High School🔭 Don't be intimidated by teaching homeschool science. I will show you how to make it as enjoyable as possible! bit.ly/3PE71p8 #homescholar #homeschoolscience #highschoolscience #teachingscience
![TheHomeScholar's tweet image. [Book Excerpt] Simple Science for Homeschooling High School🔭 Don't be intimidated by teaching homeschool science. I will show you how to make it as enjoyable as possible! bit.ly/3PE71p8
#homescholar #homeschoolscience #highschoolscience #teachingscience](https://pbs.twimg.com/media/F7d0QJ0WwAAECh_.jpg)
CV-2019 is coronavirus #12 - it's "novel" because it's the new one. The "common cold" varieties evolved not to kill the host organism, but be more contagious. They evolve more rapidly in cities, but never cease evolving by national borders. Merry Xmas! #highschoolscience
Canadian fish farming "science": "the fish farm industry has too much sway over the scientific review process" - Standing Committee on Fisheries and Oceans (FOPO) vancouverislandfreedaily.com/news/fisheries… #salmon #highschoolscience #waleg @CBCNews @BBCWorld @OrcaSOS @WildFishCons @UBCIC @waDNR
Happy Friday from the @mineolahs Math and Science Department! @betterbesloane @MichelleWenzMHS @Gutierrez_MHS @MsEdwards_ @Knopf_Math @rgoodwin6 #Friday #SabrinaSabrina #highschoolscience #highschoolmath

NAHS Students explore alternative energy with FUEL CELL CARS youtu.be/PXCFDO4DXA8. #hydrogencar #fuelcellcar #highschoolscience #nasd #norristown
NEW TEACHER SPOTLIGHT 📣 Amie joins Shawsheen with over two decades experience teaching #highschoolscience. She has a genuine enthusiasm for trying new things in the classroom and seeks-out opportunities for collaboration with her peers. #WeAreShawsheen #TeacherSpotlight

Exciting news! 🎉 Carolina's Certified Version of Biology 2 Ecosystems: Matter & Energy unit is now available for OpenSciEd High School. Check it out! #CarolinaScience #OpenSciEd #Highschoolscience #OpenSciEdHighSchool #NGSS @OpenSciEd Learn more ⬇️ hubs.li/Q02BN-sH0

First day of iGEM in the lab! We're engineering psychobiotics to help imrpove people's mental health. Restriction digest of the vector and gels-done! #igem #igem2021 #highschoolscience #diybio


Great opportunity for hands on science for students! I wish I had this opportunity while I was in school! Join BEYOND ALBERT program and learn beyond the textbooks! #highschoolscience #scienceinternships #einsteinmed
To all High School Students of the Bronx: join our BEYOND ALBERT Program! youtube.com/watch?v=Nnwg1g…

youtube.com
YouTube
Bronx High School Students Conduct Research at the Montefiore...
October is the month for Thrills & Chills, and we are providing exactly that. Test drive our Interactive Digital Edition of Active Physics [Thrills & Chills Chapter] for 30 Days. Click the link to register for the FREE demo. #STEM #HighSchoolScience conta.cc/3liDfs8
CA Educators: Check out @The_CATDC Workshop: "Centering Student Experiences and Inclusive Curricula in the Science Classroom" facilitated by MA's @LizGottlieb @EllieBeyers #science #highschoolscience #scienceteachers #scienceed
ATCF… Bridging the Achievement Gap. Don’t forget to like, comment, share, follow us, and tag someone who needs to see this! #ATCF2025 #IbadanCompetition #HighSchoolScience #HappeningToday #NigerianStudents #FutureScientists #AcademicExcellence #EducationMatters #YoungMinds
#IbadanEvents #StudentChampions #HighSchoolScience #ATCF2025 #IbadanStudents #ScienceCompetition #StudentExcellence #FutureChampions
🎯 Struggling to make cell theory click? Grab this Intro to Cells Bundle with guided notes and editable presentation! Perfect for high school biology — save time, boost engagement, and build a rock-solid science foundation. 🧬 #BiologyTeacher #CellsLesson #HighSchoolScience
🔬 #HighSchoolScience: Shaping #STEM Futures 🚀 Did you know high school science choices—like biology and AP Physics—impact STEM careers? 🧪📚 This entry explores trends and equity challenges in U.S. education. 🌍✨ Learn more: mdpi.com/2673-8392/5/1/… #EquityInEducation

@ghswolfpack teacher Crystal McDowell receives high honor from science teachers association. Read more here ccboe.net/apps/pages/ind… #EducationExcellence #TeachingAwards #HighSchoolScience #OutstandingTeachers #InspiringStudents #LifeScienceEducation #nabt #teachscience #scied

@EducationHQ_AU : 🧪 Keeping the spark alive in high school science! 🔬 Read how classroom support can sustain interest & inspire the next generation of scientists. educationhq.com/news/keep-em-k… #ScienceEducation #STEM #HighSchoolScience #ASTA #FutureScientists

We love a good hands-on science lab! Ms. Varner’s 9th Grade Honors Chemistry class studied the process of yeast fermentation today. #handsonlearning #highschoolscience #chemistrylab

Earn CEUs for free with FDA’s Science & Our Food Supply online course, hosted by @thegradschool. Perfect for certified teachers looking to enhance their knowledge of food safety and #nutrition. Start learning today: teachfoodscience.org #MiddleSchoolScience #HighSchoolScience


Love watching my babies work hard! Marking their text and writing their summaries 😍. So quiet you could hear a pin drop! #tkbio #scienceteacher #highschoolscience #iteachscience #twitterteacher #biologyteacher #contentarealiteracy #writinginscience

We're sharing #foodscience at annual NC @4H Congress. 500+ youth ages 13-18 participate in workshops/service opportunities. April Hix Morrison taught a "Science You Can Eat" workshop making "glass" lollipops. Let's just say...the kids ate it up! #sciencerocks #highschoolscience

St. Jeanne de Lestonnac High School has created an innovative Art/Science classroom out of a previous storage room. Check out the transformation! @st_jeanne_temecula #highschoolscience #STEM #catholichighschool #onpointedu




#highschoolscience working through #engineeringpractices #mdcpsstem @MDCPS @avamdcps @ccarranza1 @SynergyDade





Salmon Farming 101: If you do your own sampling, create your own studies, and decide who is "qualified", you can you live in a perfect world. #salmon #highschoolscience #FraserRiverSockeye #sealice @AllardLaw @WildFishCons @NoOpenFishFarms #messaging @OrcaSOS #cumulativeimpacts

“Seeing evolution happen in real time is just so captivating,” says @vscooper, a professor @PittHealthSci & founder of @EvolvingSTEM, which provides high school students with an evolution-in-action 3D curriculum and kit. #ScienceTwitter #highschoolscience pi.tt/mutantsummer
Today I had a wonderful time talking to the exceptionally bright students in Hunter College High School's Psychology Club about science and the 🧠! Thank you for the invite! #stem #highschoolscience #scicomm #Science

Exciting news! 🎉 Carolina's Certified Version of Biology 2 Ecosystems: Matter & Energy unit is now available for OpenSciEd High School. Check it out! #CarolinaScience #OpenSciEd #Highschoolscience #OpenSciEdHighSchool #NGSS @OpenSciEd Learn more ⬇️ hubs.li/Q02BN-sH0

Our STEM Leadership program for teens closes today! We still have scholarships available, and all who register will be automatically considered for a scholarship. Register for Project Scientist Scholars: projectscientist.org/scholars #STEMleadership #highschoolscience #highschoolSTEM

Crew Review: Fascinating Education buff.ly/2uv5GJD #hsreviews #highschoolscience #biology #chemistry #physics #onlinescience

Good morning! Day 3 of a 29.5 day science project helping ma boy measure the moon. #highschoolscience #astronomy #yyc


[Book Excerpt] Simple Science for Homeschooling High School🔭 Don't be intimidated by teaching homeschool science. I will show you how to make it as enjoyable as possible! bit.ly/3PE71p8 #homescholar #homeschoolscience #highschoolscience #teachingscience
![TheHomeScholar's tweet image. [Book Excerpt] Simple Science for Homeschooling High School🔭 Don't be intimidated by teaching homeschool science. I will show you how to make it as enjoyable as possible! bit.ly/3PE71p8
#homescholar #homeschoolscience #highschoolscience #teachingscience](https://pbs.twimg.com/media/F7d0QJ0WwAAECh_.jpg)
We love this profile bio. Keep an eye out for Alex's next project. 🚀 bit.ly/1ptz50j #highschoolscience

I look into the finance box Just to check my status I look into the microscope See Golgi Apparatus Golgi, oh, woe is me You can't even see the sea Golgi, olgi, oh ooo olgi Golgi Golgi @phish @phishlyrics101 #science #highschoolscience … ift.tt/2BZXwv4

Something went wrong.
Something went wrong.
United States Trends
- 1. Tax Day N/A
- 2. Redskins N/A
- 3. $BIRD N/A
- 4. #RaiseHail N/A
- 5. Jackie Robinson N/A
- 6. Allbirds N/A
- 7. Commanders N/A
- 8. Good Wednesday N/A
- 9. Powell N/A
- 10. Hump Day N/A
- 11. Thragg N/A
- 12. Texas Ranger N/A
- 13. MEJOR SIN BLOQUEO N/A
- 14. #Jackie42 N/A
- 15. Consumption N/A
- 16. #Invincible N/A
- 17. #WednesdayMotivation N/A
- 18. NewBird N/A
- 19. NAIC N/A
- 20. Erika N/A

















































